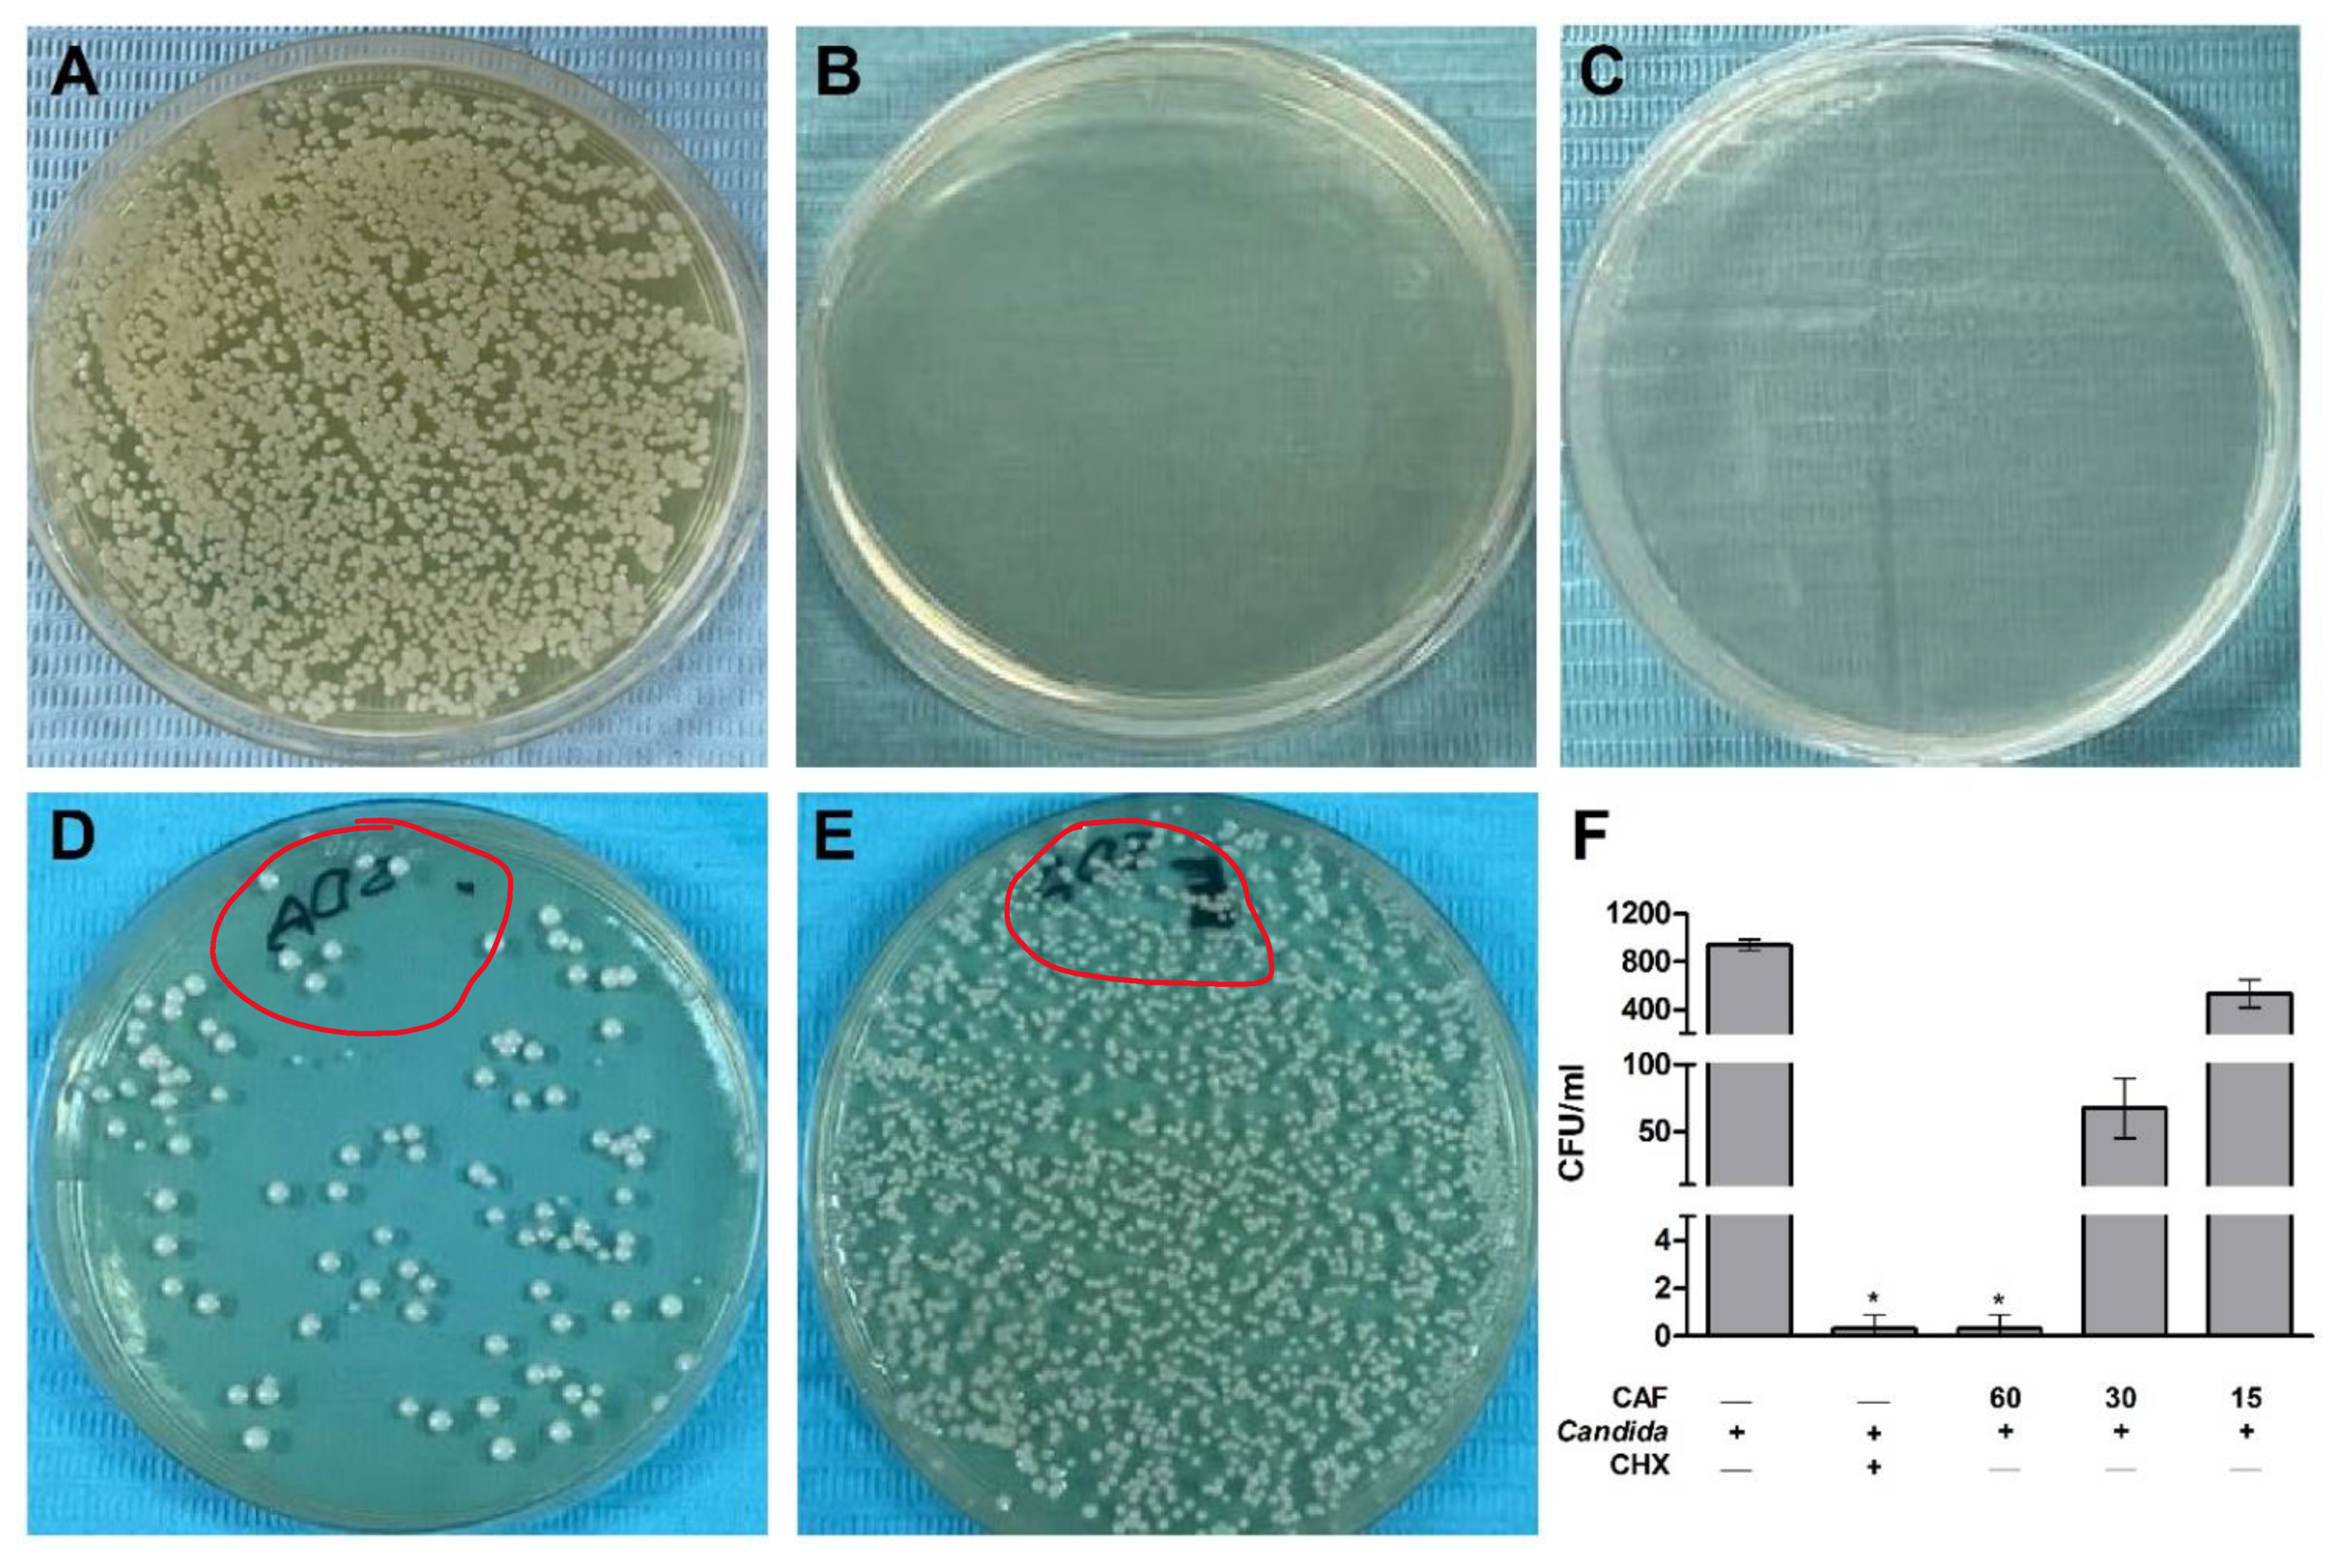
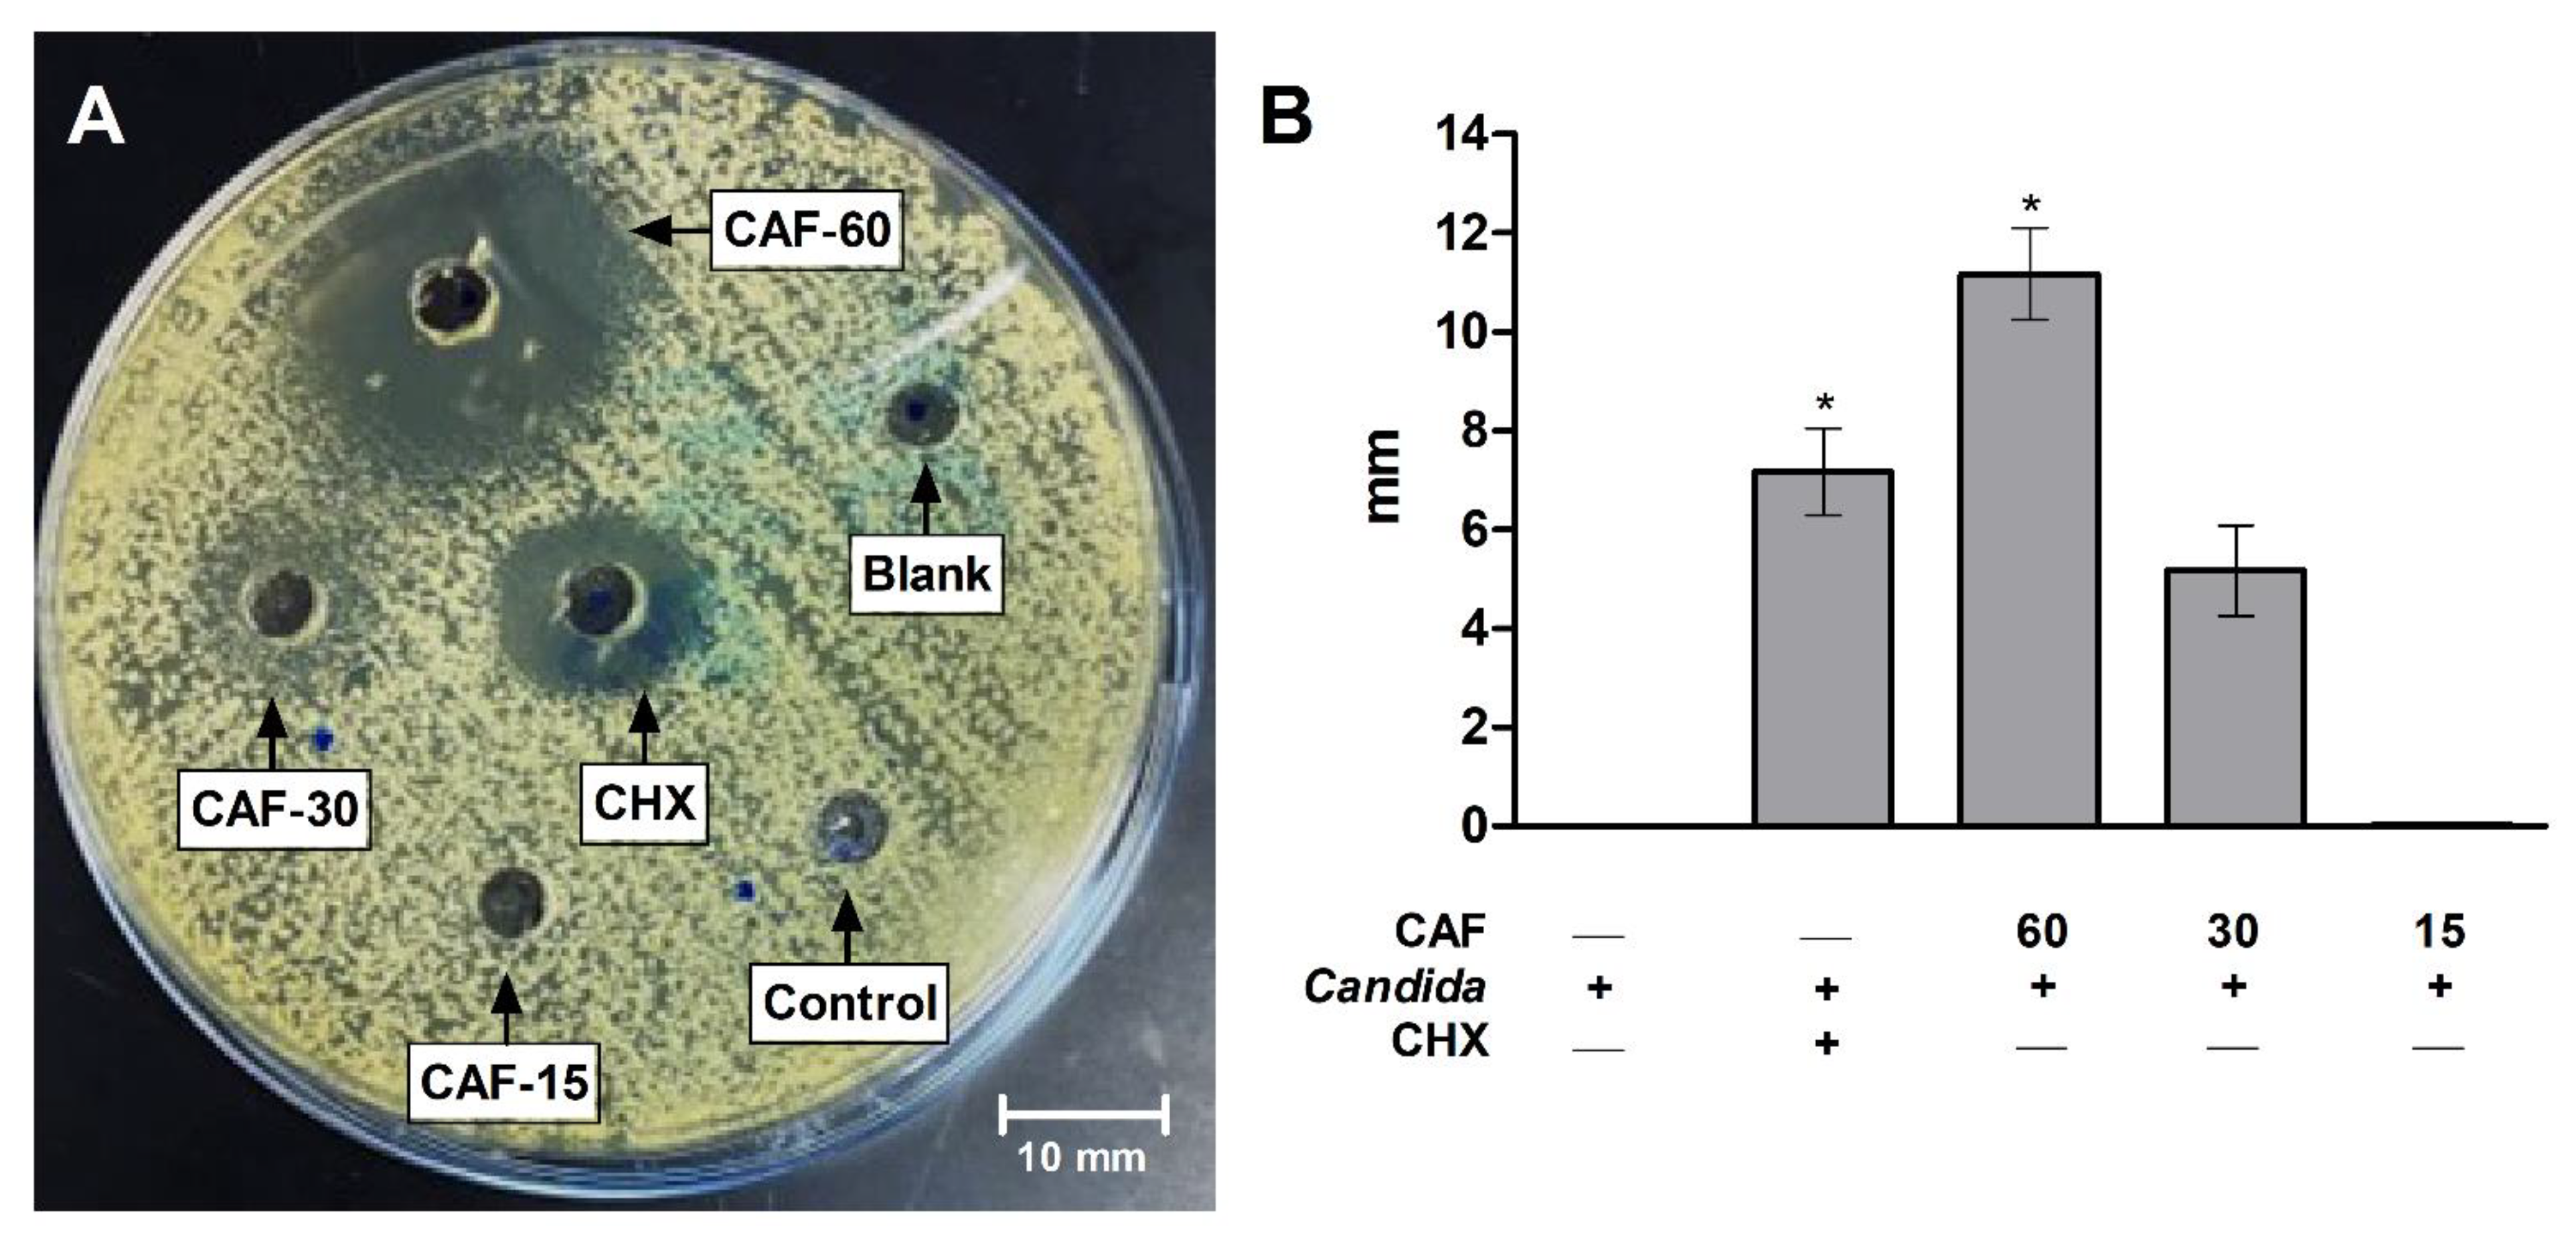

The Antifungal and Antibiofilm Activities of Caffeine against Candida albicans on Polymethyl Methacrylate Denture Base Material
Abstract
:1. Introduction
2. Materials and Methods
2.1. Chemicals and Materials
2.2. Antifungal Susceptibility Testing
2.2.1. Broth Microdilution Assay
2.2.2. Agar-Well Diffusion
2.2.3. Determination of Yeast Viability
2.3. Polymethyl Methacrylate (PMMA) Resin Preparation
2.4. Antibiofilm Activity Assay
2.5. Colony Forming Unit Assay
2.6. Scanning Electron Microscope
2.7. Statistical Analysis
3. Results
4. Discussion
5. Conclusions
Author Contributions
Funding
Institutional Review Board Statement
Informed Consent Statement
Data Availability Statement
Acknowledgments
Conflicts of Interest
References
- Lohse, M.B.; Gulati, M.; Johnson, A.D.; Nobile, C.J. Development and regulation of single- and multi-species Candida albicans biofilms. Nat. Rev. Microbiol. 2018, 16, 19–31. [Google Scholar] [CrossRef] [PubMed]
- Talapko, J.; Juzbašić, M.; Matijević, T.; Pustijanac, E.; Bekić, S.; Kotris, I.; Škrlec, I. Candida albicans-The Virulence Factors and Clinical Manifestations of Infection. J. Fungi 2021, 7, 79. [Google Scholar] [CrossRef] [PubMed]
- Gulati, M.; Nobile, C.J. Candida albicans biofilms: Development, regulation, and molecular mechanisms. Microbes Infect. 2016, 18, 310–321. [Google Scholar] [CrossRef]
- Tsui, C.; Kong, E.F.; Jabra-Rizk, M.A. Pathogenesis of Candida albicans biofilm. Pathog. Dis. 2016, 74, ftw018. [Google Scholar] [CrossRef] [PubMed]
- Cavalheiro, M.; Teixeira, M.C. Candida Biofilms: Threats, Challenges, and Promising Strategies. Front. Med. 2018, 5, 28. [Google Scholar] [CrossRef]
- Chandra, J.; Mukherjee, P.K. Candida Biofilms: Development, Architecture, and Resistance. Microbiol. Spectr. 2015, 3, 3–4. [Google Scholar] [CrossRef]
- Kucharíková, S.; Neirinck, B.; Sharma, N.; Vleugels, J.; Lagrou, K.; Van Dijck, P. In vivo Candida glabrata biofilm development on foreign bodies in a rat subcutaneous model. J. Antimicrob. Chemother. 2015, 70, 846–856. [Google Scholar] [CrossRef]
- CDC. Candida Infections of the Mouth, Throat, and Esophagus. Available online: https://www.cdc.gov/fungal/diseases/candidiasis/thrush/index.html (accessed on 14 May 2022).
- Zahra, N.; Hossein, Y.M. Antifungal Activity of Caffeine in Combination with Fluconazole Againstcandida Albicans. Infect. Epidemiol. Microbiol. (Infect. Epidemiol. Med.) 2016, 2, 18–21. [Google Scholar] [CrossRef]
- Alikhani, T.; Daie Ghazvini, R.; Mirzaii, M.; Hashemi, S.J.; Fazli, M.; Rafat, Z.; Roostaei, D.; Ardi, P.; Kamali Sarvestani, H.; Zareei, M. Drug Resistance and Biofilm Formation in Candida Species of Vaginal Origin. Iran. J. Public Health 2022, 51, 913–918. [Google Scholar] [CrossRef]
- Revie, N.M.; Iyer, K.R.; Robbins, N.; Cowen, L.E. Antifungal drug resistance: Evolution, mechanisms and impact. Curr. Opin. Microbiol. 2018, 45, 70–76. [Google Scholar] [CrossRef]
- Cowen, L.E.; Sanglard, D.; Howard, S.J.; Rogers, P.D.; Perlin, D.S. Mechanisms of Antifungal Drug Resistance. Cold Spring Harb. Perspect. Med. 2014, 5, a019752. [Google Scholar] [CrossRef] [PubMed]
- Fisher, M.C.; Alastruey-Izquierdo, A.; Berman, J.; Bicanic, T.; Bignell, E.M.; Bowyer, P.; Bromley, M.; Brüggemann, R.; Garber, G.; Cornely, O.A.; et al. Tackling the emerging threat of antifungal resistance to human health. Nat. Rev. Microbiol. 2022, 20, 557–571. [Google Scholar] [CrossRef] [PubMed]
- Khan, A.; Azam, M.; Allemailem, K.S.; Alrumaihi, F.; Almatroudi, A.; Alhumaydhi, F.A.; Ahmad, H.I.; Khan, M.U.; Khan, M.A. Coadministration of Ginger Extract and Fluconazole Shows a Synergistic Effect in the Treatment of Drug-Resistant Vulvovaginal Candidiasis. Infect. Drug Resist. 2021, 14, 1585–1599. [Google Scholar] [CrossRef] [PubMed]
- Brookes, Z.L.S.; Bescos, R.; Belfield, L.A.; Ali, K.; Roberts, A. Current uses of chlorhexidine for management of oral disease: A narrative review. J. Dent. 2020, 103, 103497. [Google Scholar] [CrossRef]
- Poppolo, D.F.; Ouanounou, A. Chlorhexidine in Dentistry: Pharmacology, Uses, and Adverse Effects. Int. Dent. J. 2022, 72, 269–277. [Google Scholar] [CrossRef]
- Shrestha, A.; Rimal, J.; Rao, A.; Sequeira, P.S.; Doshi, D.; Bhat, G.K. In vitro antifungal effect of mouth rinses containing chlorhexidine and thymol. J. Dent. Sci. 2011, 6, 1–5. [Google Scholar] [CrossRef]
- Al Reef, T.; Ghanem, E. Caffeine: Well-known as psychotropic substance, but little as immunomodulator. Immunobiology 2018, 223, 818–825. [Google Scholar] [CrossRef]
- Açıkalın, B.; Sanlier, N. Coffee and its effects on the immune system. Trends Food Sci. Technol. 2021, 114, 625–632. [Google Scholar] [CrossRef]
- Alfaifi, A.A.; Lin, W.S.; Aldhaian, B.A.; Levon, J.A.; Gregory, R.L. Impact of caffeine on metabolic activity and biofilm formation of Candida albicans on acrylic denture resin in the presence of nicotine. J. Prosthet. Dent. 2020, 123, 875–879. [Google Scholar] [CrossRef]
- Raut, J.S.; Chauhan, N.M.; Shinde, R.B.; Karuppayil, S.M. Inhibition of planktonic and biofilm growth of Candida albicans reveals novel antifungal activity of caffeine. J. Med. Plants Res. 2013, 13, 777–782. [Google Scholar] [CrossRef]
- CLSI. Chapter 3. Antifungal broth dilutions susceptibility testing process for yeasts. In M27: Reference Method for Broth Dilution Antifungal Susceptibility Testing of Yeasts, 4th ed.; Alexander, B.D., Ed.; Clinical Laboratory Standards Institute: Wayne, PA, USA, 2017. [Google Scholar]
- Balouiri, M.; Sadiki, M.; Ibnsouda, S.K. Methods for in vitro evaluating antimicrobial activity: A review. J. Pharm. Anal. 2016, 6, 71–79. [Google Scholar] [CrossRef] [PubMed]
- Cantón, E.; Espinel-Ingroff, A.; Pemán, J. Trends in antifungal susceptibility testing using CLSI reference and commercial methods. Expert Rev. Anti-Infect. Ther. 2009, 7, 107–119. [Google Scholar] [CrossRef] [PubMed]
- Fouda, S.M.; Gad, M.M.; Ellakany, P.; Al Ghamdi, M.A.; Khan, S.Q.; Akhtar, S.; Al Eraky, D.M.; Al-Harbi, F.A. Effect of Low Nanodiamond Concentrations and Polymerization Techniques on Physical Properties and Antifungal Activities of Denture Base Resin. Polymers 2021, 13, 4331. [Google Scholar] [CrossRef] [PubMed]
- Mota, S.; Alves, R.; Carneiro, C.; Silva, S.; Brown, A.J.; Istel, F.; Kuchler, K.; Sampaio, P.; Casal, M.; Henriques, M.; et al. Candida glabrata susceptibility to antifungals and phagocytosis is modulated by acetate. Front. Microbiol. 2015, 6, 919. [Google Scholar] [CrossRef]
- Wu, T.; Shi, W.; Loewy, Z.G.; He, X. Managing denture biofilm related diseases. Dent. Open J. 2015, 2, 80–86. [Google Scholar] [CrossRef]
- Akpan, A.; Morgan, R. Oral candidiasis. Postgrad. Med. J. 2002, 78, 455–459. [Google Scholar] [CrossRef]
- Daly, J.W. Caffeine analogs: Biomedical impact. Cell Mol. Life Sci. 2007, 64, 2153–2169. [Google Scholar] [CrossRef]
- Temple, J.L.; Bernard, C.; Lipshultz, S.E.; Czachor, J.D.; Westphal, J.A.; Mestre, M.A. The Safety of Ingested Caffeine: A Comprehensive Review. Front. Psychiatry 2017, 8, 80. [Google Scholar] [CrossRef]
- Lee, M.J.; Kim, M.J.; Oh, S.H.; Kwon, J.S. Novel Dental Poly (Methyl Methacrylate) Containing Phytoncide for Antifungal Effect and Inhibition of Oral Multispecies Biofilm. Materials 2020, 13, 371. [Google Scholar] [CrossRef]
- Avizheh, L.; Peirouvi, T.; Diba, K.; Fathi-Azarbayjani, A. Electrospun wound dressing as a promising tool for the therapeutic delivery of ascorbic acid and caffeine. Ther. Deliv. 2019, 10, 757–767. [Google Scholar] [CrossRef]
- Islahudin, F.; Khozoie, C.; Bates, S.; Ting, K.N.; Pleass, R.J.; Avery, S.V. Cell wall perturbation sensitizes fungi to the antimalarial drug chloroquine. Antimicrob. Agents Chemother. 2013, 57, 3889–3896. [Google Scholar] [CrossRef] [PubMed]
- Mittag, H. Structural alterations in Candida albicans by caffeine and caffeine salts. Mycoses 1994, 37, 337–341. [Google Scholar] [CrossRef] [PubMed]
- Sabie, F.T.; Gadd, G.M. Effect of nucleosides and nucleotides and the relationship between cellular adenosine 3′:5′-cyclic monophosphate (cyclic AMP) and germ tube formation in Candida albicans. Mycopathologia 1992, 119, 147–156. [Google Scholar] [CrossRef] [PubMed]
- Sarachek, A.; Henderson, L.A. Recombinagenicity of caffeine for Candida albicans. Mycopathologia 1990, 110, 63–76. [Google Scholar] [CrossRef]
- Bazzaz, B.S.F.; Fakori, M.; Khameneh, B.; Hosseinzadeh, H. Effects of Omeprazole and Caffeine Alone and in Combination with Gentamicin and Ciprofloxacin Against Antibiotic Resistant Staphylococcus aureus and Escherichia coli Strains. J. Pharmacopunct. 2019, 22, 49–54. [Google Scholar] [CrossRef]
- Kang, T.M.; Yuan, J.; Nguyen, A.; Becket, E.; Yang, H.; Miller, J.H. The aminoglycoside antibiotic kanamycin damages DNA bases in Escherichia coli: Caffeine potentiates the DNA-damaging effects of kanamycin while suppressing cell killing by ciprofloxacin in Escherichia coli and Bacillus anthracis. Antimicrob. Agents Chemother. 2012, 56, 3216–3223. [Google Scholar] [CrossRef]
- Cui, W.Q.; Wang, S.T.; Pan, D.; Chang, B.; Sang, L.X. Caffeine and its main targets of colorectal cancer. World J. Gastrointest. Oncol. 2020, 12, 149–172. [Google Scholar] [CrossRef]
- Szabó, K.; Kónya, Z.; Erdődi, F.; Farkas, I.; Dombrádi, V. Dissection of the regulatory role for the N-terminal domain in Candida albicans protein phosphatase Z1. PLoS ONE 2019, 14, e0211426. [Google Scholar] [CrossRef]
- Ádám, C.; Erdei, É.; Casado, C.; Kovács, L.; González, A.; Majoros, L.; Petrényi, K.; Bagossi, P.; Farkas, I.; Molnar, M.; et al. Protein phosphatase CaPpz1 is involved in cation homeostasis, cell wall integrity and virulence of Candida albicans. Microbiology (Reading) 2012, 158, 1258–1267. [Google Scholar] [CrossRef]
- Feng, J.; Duan, Y.; Sun, W.; Qin, Y.; Zhuang, Z.; Zhu, D.; Sun, X.; Jiang, L. CaTip41 regulates protein phosphatase 2A activity, CaRad53 deactivation and the recovery of DNA damage-induced filamentation to yeast form in Candida albicans. FEMS Yeast Res. 2016, 16, fow009. [Google Scholar] [CrossRef] [Green Version]
- Liu, W.; Zhao, J.; Li, X.; Li, Y.; Jiang, L. The protein kinase CaSch9p is required for the cell growth, filamentation and virulence in the human fungal pathogen Candida albicans. FEMS Yeast Res. 2010, 10, 462–470. [Google Scholar] [CrossRef] [PubMed]
- Kunze, D.; MacCallum, D.; Odds, F.C.; Hube, B. Multiple functions of DOA1 in Candida albicans. Microbiology (Reading) 2007, 153, 1026–1041. [Google Scholar] [CrossRef] [PubMed]
- Hernáez, M.L.; Gil, C.; Pla, J.; Nombela, C. Induced expression of the Candida albicans multidrug resistance gene CDR1 in response to fluconazole and other antifungals. Yeast 1998, 14, 517–526. [Google Scholar] [CrossRef]
- Stichternoth, C.; Fraund, A.; Setiadi, E.; Giasson, L.; Vecchiarelli, A.; Ernst, J.F. Sch9 kinase integrates hypoxia and CO2 sensing to suppress hyphal morphogenesis in Candida albicans. Eukaryot. Cell 2011, 10, 502–511. [Google Scholar] [CrossRef]
- Sanglard, D.; Ischer, F.; Marchetti, O.; Entenza, J.; Bille, J. Calcineurin A of Candida albicans: Involvement in antifungal tolerance, cell morphogenesis and virulence. Mol. Microbiol. 2003, 48, 959–976. [Google Scholar] [CrossRef]
- Maver-Biscanin, M.; Mravak-Stipetic, M.; Jerolimov, V. Effect of low-level laser therapy on Candida albicans growth in patients with denture stomatitis. Photomed. Laser Surg. 2005, 23, 328–332. [Google Scholar] [CrossRef]
- Kathwate, G.H.; Karuppayil, S.M. Antifungal properties of the anti-hypertensive drug: Aliskiren. Arch. Oral Biol. 2013, 58, 1109–1115. [Google Scholar] [CrossRef]
- Mendonça e Bertolini, M.; Cavalcanti, Y.W.; Bordin, D.; Silva, W.J.; Cury, A.A. Candida albicans biofilms and MMA surface treatment influence the adhesion of soft denture liners to PMMA resin. Braz. Oral Res. 2014, 28, 61–66. [Google Scholar] [CrossRef]
- Meirowitz, A.; Rahmanov, A.; Shlomo, E.; Zelikman, H.; Dolev, E.; Sterer, N. Effect of Denture Base Fabrication Technique on Candida albicans Adhesion In Vitro. Materials 2021, 14, 221. [Google Scholar] [CrossRef]

Publisher’s Note: MDPI stays neutral with regard to jurisdictional claims in published maps and institutional affiliations. |
© 2022 by the authors. Licensee MDPI, Basel, Switzerland. This article is an open access article distributed under the terms and conditions of the Creative Commons Attribution (CC BY) license (https://creativecommons.org/licenses/by/4.0/).
Share and Cite
AlEraky, D.M.; Abuohashish, H.M.; Gad, M.M.; Alshuyukh, M.H.; Bugshan, A.S.; Almulhim, K.S.; Mahmoud, M.M. The Antifungal and Antibiofilm Activities of Caffeine against Candida albicans on Polymethyl Methacrylate Denture Base Material. Biomedicines 2022, 10, 2078. https://doi.org/10.3390/biomedicines10092078
AlEraky DM, Abuohashish HM, Gad MM, Alshuyukh MH, Bugshan AS, Almulhim KS, Mahmoud MM. The Antifungal and Antibiofilm Activities of Caffeine against Candida albicans on Polymethyl Methacrylate Denture Base Material. Biomedicines. 2022; 10(9):2078. https://doi.org/10.3390/biomedicines10092078
Chicago/Turabian StyleAlEraky, Doaa M., Hatem M. Abuohashish, Mohammed M. Gad, Muneer H. Alshuyukh, Amr S. Bugshan, Khalid S. Almulhim, and Maha M. Mahmoud. 2022. "The Antifungal and Antibiofilm Activities of Caffeine against Candida albicans on Polymethyl Methacrylate Denture Base Material" Biomedicines 10, no. 9: 2078. https://doi.org/10.3390/biomedicines10092078
APA StyleAlEraky, D. M., Abuohashish, H. M., Gad, M. M., Alshuyukh, M. H., Bugshan, A. S., Almulhim, K. S., & Mahmoud, M. M. (2022). The Antifungal and Antibiofilm Activities of Caffeine against Candida albicans on Polymethyl Methacrylate Denture Base Material. Biomedicines, 10(9), 2078. https://doi.org/10.3390/biomedicines10092078

